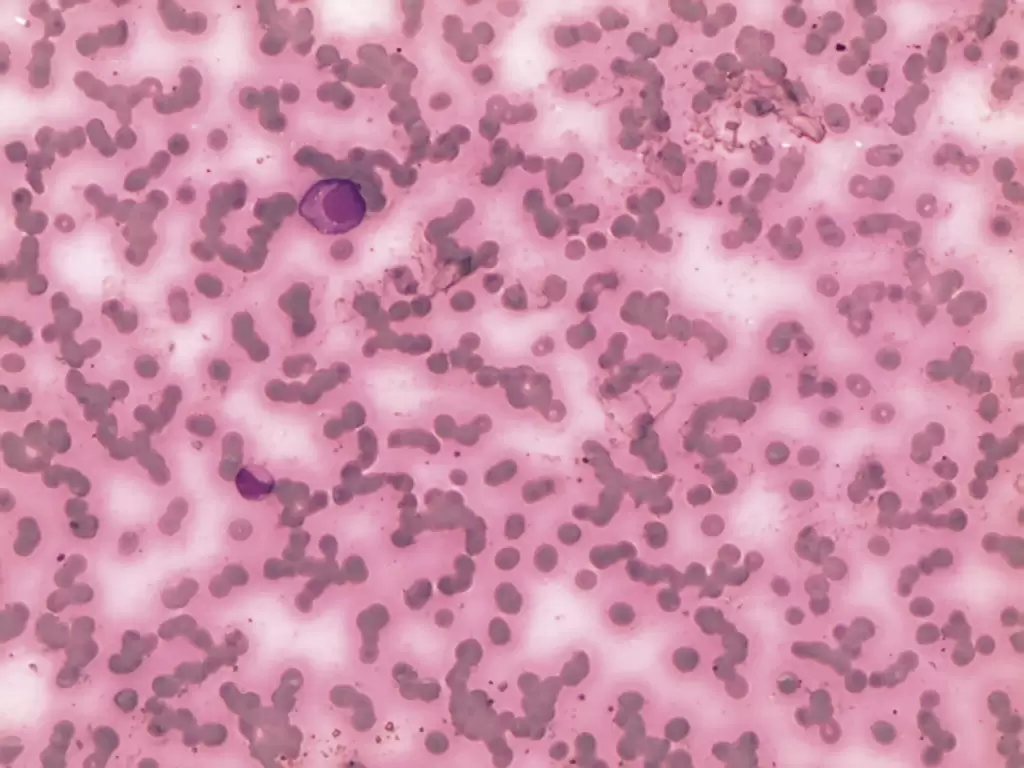

Manuscript submission | Sections
The journal accepts original contributions in English only. Following editorial approval, all articles undergo a double-blind peer review by at least two anonymous reviewers. Reviewer comments are sent to the authors, who may then revise their manuscript or provide a rebuttal. After addressing the suggested corrections, the revised article must be resubmitted to einstein (São Paulo) via the journal’s submission system. Articles are published only upon final acceptance by both reviewers and editors.
Authors of articles published in the journal einstein (São Paulo) retain copyright and grant third parties the right to use, reproduce, or disseminate their article under the terms of the journal’s adopted CC BY Creative Commons Attribution 4.0 license.
The journal uses the Turnitin plagiarism detection software to check the originality of articles. Cases of publication misconduct will be assessed in accordance with the guidelines and recommendations of the Committee on Publication Ethics (COPE).
All submissions must adhere to the following guidelines, which are based on the format proposed by the ICMJE, published as “Uniform Requirements for Manuscripts Submitted to Biomedical Journals,” available at http://www.icmje.org/recommendations/browse/manuscript-preparation.
Open Science Compliance
The journal einstein (São Paulo) supports open science best practices, making research data, lab notes, and other research processes available so that other researchers can collaborate and contribute to the advancement of research.
The journal requires authors to complete the Open Science Compliance Form, available at: Open Science Compliance Form
Technical requirements
The authors must submit the articles containing:
- Text typed in double-spaced 12 point Arial font, 2.5cm margin on each side, highlighting each section of the article.
- Authors’ statement that the manuscript is not under consideration, and will not be submitted to publication, in another journal (available in the electronic submission system).
- Studies performed that require animal or human subjects ethical committee approval must include in the methods section the appropriate ethical committee approval number. For example, human subject studies performed in Brazil must include the CAAE number.
- Conflict of interest disclosure statement from each author.
Preparing a manuscript
Title
Title of the article, in English, which should be concise but informative.
Abstract
Abstract, in English, limited to 250 words. For original articles, abstracts should be structured (Objective, Methods, Results, Conclusion), describes the main parts of the work and highlights the most relevant data. For articles of other sections, the abstract should not be structured.
Keywords
Provide at least 5 and no more than 10 keywords, in English reflecting the content of the paper. Keywords must be based on the Medical Subject Headings (MeSH) of the National Library of Medicine, and available at https://www.ncbi.nlm.nih.gov/mesh/
Registry in Clinical Trials Database
Indicate, for Clinical Trials, the registry number in the clinical trials database (https://clinicaltrials.gov).*
* Important note: in support of the policies on registry of clinical trials of the World Health Organization (WHO) and ICMJE, the journal einstein (São Paulo) understands the relevance of these initiatives for registration and international dissemination of information on clinical studies. The journal only accepts for publication the clinical research articles that have received an identification number in one of the Clinical Trials Registries validated by the criteria established by the WHO and the ICMJE, available at https://clinicaltrials.gov or at the website PubMed, in the item <clinicaltrials.gov>. The identification number should be shown at the end of the abstract.
Text
Text must comply with the structure required for each category of article. Citations of authors in the text must be numbered sequentially, by superscript Arabic numerals in parentheses. The complete definition of abbreviations and acronyms should written before their first use in the text. Do not use abbreviations or acronyms in title and abstract. In table and figure legends, the abbreviations must be followed by the full term.
Acknowledgements
This describes collaboration by individuals that deserve acknowledging but do not qualify for authorship. This section should also be used to provide information about financial and/or technical support, etc.
References
They must be numbered consecutively in the same order they appear in the text, and identified by Arabic numerals. References follow the “Vancouver Style”, and the titles of journals should be abbreviated according to the style presented by the List of Journals Indexed in Index Medicus, of the National Library of Medicine, available at http://www.ncbi.nlm.nih.gov/nlmcatalog/journals. For any references, mention up to six authors. In case of more than six authors, mention the first six, followed by et al., as shown in the following examples:
Articles from electronic journals
Moniz MH, Low LK, Stout MJ. Intensive nurse home visiting program and adverse birth outcomes. JAMA. 2022;328(1):23-4.
Oliveira MM, Andrade KF, Lima GH, Rocha TC. Metformin versus glyburide in treatment and control of gestational diabetes mellitus: a systematic review with meta-analysis. einstein (São Paulo). 2022;20:eRW6155.
Books
Ritchie S. Science fictions: how fraud, bias, negligence, and hype undermine the search for trusth. New York: Metropolitan Books; 2020.
Chapters of books
Josephson CD, Strauss RG. Plasma transfusions. In: Behrman RE, Editor. Nelson textbook of pediatrics. 21st ed. Philadelphia (PA): Elsevier; c2020. p.2585-6.
Works presented in conferences
Rivarola E, Dimuro CA, Scandolo MC, Quintero Florez A. Design of gourmet menus high in fiber for diabetic patients of the French sanatorium: evaluation of the nutritional content, acceptability, organoleptic characteristics and glycemic control. Clinical Nutrition ESPEN. 2021;46:S690. [ESPEN 2021 Virtual Congress; 2021 Sep 9-14].
Thesis
Pinheiro LL. Avaliação da aorta torácica de brasileiros tabagistas por tomografia de tórax de baixa dose: diâmetros e prevalência de aneurismas [tese]. São Paulo: Faculdade Israelita de Ciências da Saúde Albert Einstein; 2021.
Supplementary Materials
Supplementary materials must be cited in the text and labeled as follows: Table S1, Supplementary Material; Figure S1, Supplementary Material; and so on for all subsequent supplementary tables and figures.
Funding Statement
All funding from national or international development agencies or any other source of support must include the sponsors’ names, the contract number or code (if applicable), and a specification of the nature of the support provided.
Tables
All tables (≤ 4 tables) should contain the title and heading for columns and must be mentioned in the text. They should be numbered sequentially by Arabic numerals, in the order they appear in the text. Table footnotes should have a definition for abbreviations and statistical tests used.
Figures
Any figure (images, graphs, photographs and illustrations) should be mentioned in the text and submitted in greater than or equal to intended display size. The journal accepts no more than four figures per article. They should be numbered sequentially by Arabic numerals, in the order they appear in the text. If the figures have already been published, a written permission for reproduction must be provided by the author/editor, and legends should include the source of publication. When saved in digital files, the resolution should comply with the following instructions:
Guidelines for formatting figures
| Image Type | Description | Example | Recommended Format | Color mode | Resolution |
| Line art | An image composed of lines and text, which contains no tonal or shaded areas | ![]() |
tif or eps | Monochrome 1 bit or RGB |
900 to 1,200 dpi |
| Halftone | A continuous tone photograph containing no text | ![]() |
tif | RGB or Grayscale | 300 dpi |
| Combo | Image contains halftone plus text or line art elements | ![]() |
tif or eps | RGB or Grayscale | 500 to 900 dpi |
Example of line art extracted from: Loureiro LV, Callegaro Filho D, Rocha Ade A, Prado BL, Mutão TS, Donnarumma Cdel C, et al. Is there publication bias towards Brazilian articles on cancer. einstein (São Paulo). 2013;11(1):15-22;
Example of halftone extracted from: Pavon LF, Marti LC, Sibov TT, Miyaki LA, Malheiros SM, Mamani JB, et al. Isolation, cultivation and characterization of CD133+ stem cells from human glioblastoma. einstein (São Paulo). 2012;10(2):197-202;
Example of combo extracted from: Souza CL, Perini GF, Hamerschlak N, Silveira PA. Plasma cell leukemia. einstein (São Paulo). 2013;11(1):132.
Source: http://www.ncbi.nlm.nih.gov/pmc/pub/filespec-images/#fig-format